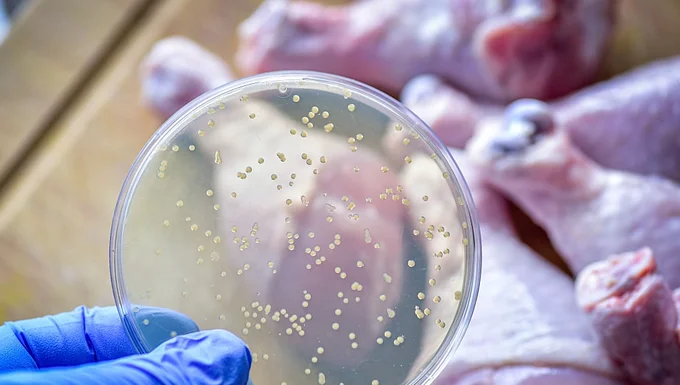

El descubrimiento de unas células inmunitarias que regulan la presión ocular transforma la prevención de la ceguera y revela el secreto para combatir el glaucoma desde su origen.
Investigadores de la Universidad de Duke en EU identificaron células en los ojos que funcionan como un equipo de limpieza microscópico encargado de mantener libres los conductos de drenaje.

¿Cuáles son las células llamadas el “equipo de limpieza” del ojo?
El ojo posee un complejo sistema de tuberías microscópicas donde circulan fluidos de manera constante. En estos conductos habitan los macrófagos residentes, células cuya función era un misterio y que ahora se confirman como responsables del mantenimiento visual continuo.
- Ubicación estratégica: Viven permanentemente ocultos en los delicados tejidos de drenaje de los globos oculares.
- Mantenimiento continuo: Funcionan como un equipo de limpieza biológico que barre los desechos celulares.
- Regulación activa: Su labor permite comprender el papel del sistema inmunológico en la tensión ocular.

¿Cómo estas células controlan la presión ocular?
El interior de los ojos produce un líquido de forma ininterrumpida para nutrir los tejidos. Para conservar un equilibrio, ese fluido debe salir a un ritmo similar por las vías de drenaje. Los macrófagos actúan como plomeros eficientes que devoran residuos y mantienen libres los canales, garantizando que el líquido no se estanque.
- Acción preventiva: Al mantener el drenaje despejado, evitan que la presión interna se eleve a niveles tóxicos.
- Equilibrio natural: Este mecanismo celular resulta esencial para conservar una presión ocular saludable.
- Participación inmunitaria: Las defensas no solo atacan agentes externos, sino que regulan activamente la tensión del ojo.

¿Qué sucede ante la ausencia de estas células?
La historia da un giro cuando estos guardianes desaparecen de su puesto. Mediante etiquetas fluorescentes, los expertos rastrean sus movimientos en el laboratorio con ratones; al eliminar selectivamente a estas células, el sistema colapsa y pone en riesgo la integridad del nervio óptico.
- Obstrucción total: Sin las células de limpieza, el sistema de tuberías del ojo se tapa en poco tiempo.
- Acumulación de líquido: El agua que debe salir naturalmente se estanca en el interior del globo ocular.
- Aumento de presión: Al no tener una vía de escape, la tensión ocular sube sin control.
- Riesgo de glaucoma: La interrupción de este sistema contribuye directamente al desarrollo de la enfermedad.

¿Qué significa este hallazgo para el tratamiento del glaucoma?
Los tratamientos actuales funcionan como parches que alivian el síntoma, pero no combaten el origen del padecimiento. Este descubrimiento podría cambiar las reglas del juego al ofrecer una alternativa que ataca la raíz del problema mediante la estimulación de la limpieza natural.
- Ataque de raíz: Las nuevas terapias buscan normalizar la presión estimulando estas células directamente.
- Prevención de la ceguera: Al restaurar la higiene de los conductos, se detiene la pérdida de visión.
- Identificación humana: El siguiente paso consiste en localizar estos mismos macrófagos en tejido ocular humano.
El próximo paso para los científicos será rastrear e identificar a estos vitales macrófagos directamente en el tejido del ojo humano. A partir de ese punto, el objetivo es crear terapias innovadoras que logren normalizar la presión ocular desde la raíz y detener la ceguera.
Comparte esto:
- Comparte en Facebook (Se abre en una ventana nueva) Facebook
- Compartir en X (Se abre en una ventana nueva) X
- Compartir en Threads (Se abre en una ventana nueva) Threads
- Compartir en LinkedIn (Se abre en una ventana nueva) LinkedIn
- Compartir en Tumblr (Se abre en una ventana nueva) Tumblr
- Compartir en Bluesky (Se abre en una ventana nueva) Bluesky
- Compartir en Mastodon (Se abre en una ventana nueva) Mastodon
- Haz clic en Pinterest (Se abre en una ventana nueva) Pinterest
- Compartir en Nextdoor (Se abre en una ventana nueva) Nextdoor
- Compartir en Reddit (Se abre en una ventana nueva) Reddit
- Compartir en Telegram (Se abre en una ventana nueva) Telegram
- Compartir en WhatsApp (Se abre en una ventana nueva) WhatsApp